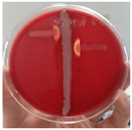
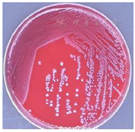

患者,女性,61岁,因"高热伴精神行为异常4天"入院。患者于2021年5月28日出现恶心,呕出少量涎液,后出现精神行为异常,主要表现为躁动不安,在床上滚动,四肢无目地摸索,抓拽,咬人,问话不答,症状持续存在。伴高热,体温最高39℃。
精神行为异常,主要表现为躁动、四肢无目地摸索、咬人等。昏睡状态,呼之不应,查体不合作,双侧Babinski征阴性,颈部抵抗,Kerning征阳性。
腰椎穿刺,脑脊液培养。
甘露醇、甘油果糖、利奈唑胺、美罗培南,哌拉西林-他唑巴坦、利福平和口服复方新诺明。
患者症状明显好转,神志清楚,无发热、头痛、鼻流清水等症状,体温及炎性指标均恢复至正常水平,于2021年6月23日出院。
神经内科;急诊科;检验科
版权归中华医学会所有。本文为遵循CC-BY-NC-ND协议的开放获取文章。
无乳链球菌(group B streptococcus, GBS),也称为B族链球菌,是一种革兰染色阳性链球菌,约10%-30%健康女性的泌尿生殖道携带无乳链球菌[1],健康人鼻咽部也携带此菌,属于条件致病菌。其主要引发新生儿败血症、肺炎、脑膜炎和孕产妇产褥期脓毒血症等。但引起的非新生儿及孕产妇患者疾病很少见,易被忽略。回顾我院1例无乳链球菌感染导致老年患者化脓性脑膜脑炎病例。
患者,女性,61岁,因"高热伴精神行为异常4天"入院。患者2021年5月11日鼻腔开始流无色清亮液体,2021年5月27日就诊于当地医院予鼻喷剂治疗。2021年5月28日出现恶心,呕出少量涎液,后出现精神行为异常,主要表现为躁动不安,在床上滚动,四肢无目地摸索,抓拽,咬人,问话不答,症状持续存在。就诊于当地某医院,测体温36.8℃,完善颅脑+胸部CT,血常规提示白细胞32.6×109/L,中性粒细胞百分比94.3%,血小板699×109/L,予补液、镇静对症治疗,患者症状无缓解。考虑颅内感染,治疗上予美罗培南2g 1次/8h、利奈唑胺抗感染,甘露醇50g 1/6h、甘油果糖250ml 1/12h脱水降颅压,并予抑酸、化痰、补钾、营养支持等治疗。经治疗患者仍躁动不安、发热,体温最高达39.0℃,予冰毯物理降温等对症治疗。为求进一步诊治以"颅内感染"收入神经内科监护病房。
既往史:视物模糊20年,考虑眼底动脉硬化,未治疗;高血压病病史20年,血压最高170/100mmHg,未正规用药;血小板增高病史10余年,未正规治疗;突发向前跌倒、呼之不应,伴咬舌6年余,每次持续10-20分钟意识转清,近2年未发作;间断胸闷、憋气2年余。
体格检查:体温:37℃,脉搏:96次/分,呼吸:18次/分,血压:181/100mmHg,身高:160cm,体重:卧床未测。发育正常,营养良好,痛苦面容,自主体位,意识昏睡,查体不合作。双侧瞳孔等大等圆,直径约为5mm,对光反射迟钝,颈抵抗,颏下三横指,昏睡状态,查体不合作(FOUR:E3M3B3R4;RLS:4;GCS:E4V1M5;CRS-R:5),问话不答,腹壁反射正常,颈抵抗,颏胸3横指,Kernig征左+,右+,Brudzinski征查体不合作。皮肤、黏膜正常,皮肤泌汗正常,毛发、指甲正常,尿管导尿。
实验室检查:血常规(2021-05-28):白细胞计数:35.5×10^9/L↑,中性粒细胞百分比:94.6%↑,血小板计数:701×10^9/L↑,C-反应蛋白测定:1.696mg/dl↑,白细胞介素-6:3824.00pg/ml↑,降钙素原:46.24ng/ml↑,红细胞沉降率测定23mm/h↑。腰椎穿刺(2021-05-28):可见乳糜样微黄脑脊液,初压末压均大于330mm液柱;脑脊液常规:脑脊液白细胞数5649×106/L,脑脊液多核细胞百分比83%,;脑脊液生化:脑脊液葡萄糖2.9mmol/L,脑脊液氯化物122.5mmol/L,脑脊液蛋白2486mg/L↑;脑脊液免疫球蛋白测定:脑脊液IgA 2.86mg/dl↑,脑脊液IgG 48.2mg/dl↑,脑脊液IgM2.23mg/dl↑。脑脊液细菌培养(2021-06-01):阳性,涂片染色为革兰阳性球菌(图1),转种血平板(图2),经鉴定无乳链球菌,药敏结果:对青霉素、氨苄西林、利奈唑胺、万古霉素等均敏感。加做CAMP试验,结果阳性(图3)。静脉血需氧菌及厌氧菌培养(2021-06-01):均报告阳性,鉴定结果均为无乳链球菌。颅脑CT(2021-06-01):脑实质CT平扫未见明确异常,局部伪影较大,必要时复查。多组鼻窦炎。胸部CT(2021-06-01 ):考虑双肺炎性改变,较(2021-05-28)日片进展,请结合临床。双侧胸腔积液,右肺叶间积液。






定位诊断:患者意识障碍、烦躁不安,四肢无目地摸索、抓拽,伴咬人,定位额颞叶及边缘系统;脑膜刺激征阳性,腰椎穿刺提示颅压增高,脑脊液白细胞数及蛋白明显增高,定位于脑膜及脑脊液循环系统。综合,定位于额颞叶、边缘系统、脑膜及脑脊液循环系统。
定性诊断:该患者中年女性,急性起病,主要表现为高热、精神行为异常,查体可见脑膜刺激征,外周血白细胞数、中性粒细胞计数、降钙素原、血沉等感染指标明显增高,腰椎穿刺可见乳糜样微黄脑脊液,压力高,CSF细胞高达5649×106/L,多核为主,血及脑脊液培养均可见无乳链球菌,均支持化脓性脑膜脑炎诊断;患者经抗感染治疗后临床症状好转且脑脊液白细胞、脑脊液蛋白明显减少,化脓性脑膜炎诊断明确。
未明确感染病原前,予美罗培南2g 1次/8h、利奈唑胺抗感染,甘露醇50g 1/6h、甘油果糖250ml 1/12h脱水降颅压,并予抑酸、化痰、补钾、营养支持等治疗。经治疗后患者仍躁动不安、发热,体温最高达39.0℃,予冰毯物理降温等对症治疗。2021年6月1日血及脑脊液细菌培养结果均为无乳链球菌,该菌为革兰阳性球菌,调整抗生素为利奈唑胺+利福平,停美罗培南。患者肺部CT提示双肺炎症,予头孢哌酮钠他唑巴坦钠治疗肺部感染。给予利培酮改善精神症状。
患者无发热、头痛,神志清楚,精神状态良好,对答切题。查体:体温:36.4℃,脉搏:75次分,呼吸:18次/分,血压:126/75mmHg,心率:77次/分,心肺腹查体未见明显异常。神经系统查体:神清(FOUR:E4M4B3R4;RLS:4;GCS:E4V3M5;CRS-R:23),言语流利,查体合作,高级皮层功能查体大致正常。双侧瞳孔等大正圆,直径约5mm,光反射迟钝,余颅神经查体未见异常。四肢肌张力正常,四肢肌力正常,四肢腱反射正常。共济运动稳准,感觉查体未见异常。双侧Babinski征阴性。颈软,无抵抗,Kerning征征阴性,于2021年6月23日出院。
细菌性脑膜炎是由各种细菌感染引起的脑膜、蛛网膜下腔和脑血管急性炎症[2],具有较高致死率和致残率。最常见的病原体包括肺炎链球菌(约占47%)、脑膜炎奈瑟氏菌(约占25%)、无乳链球菌(约占12%)、产单核细胞李斯特菌(约占8%),还有流感嗜血杆菌(约占7%)[3]。典型的三联征为发热、头痛、颈项强直,44%的患者有典型症状,但几乎所有的患者均至少存在以下4项中的2项:发热、头痛、颈项强直、精神状态改变。本例患者具有意识障碍、行为异常、颈抵抗,Kerning征阳性等典型特征,为疾病的临床诊断提供了线索。行腰椎穿刺术完善脑脊液相关检查是其主要诊断方法,脑脊液常规及生化是甄别细菌性、病毒性、结核性等脑膜炎的有利证据,脑脊液培养是诊断细菌性脑膜炎的金标准。
化脓性脑膜炎的特点为脑脊液浑浊,白细胞数百或数万(多核为主),蛋白质明显增加,葡萄糖降低,氯化物正常或减少。使用脑脊液与血清葡萄糖比值可以纠正因高血糖所致的脑脊液浓度相对降低。比值<0.6:提示脑脊液葡萄糖浓度低;比值<0.4:高度提示细菌性脑膜炎,但也可见于其他疾病,包括真菌性、结核性和癌性脑膜炎。而免疫球蛋白IgG、IgA和IgM是由局部合成,中枢神经系统感染时激活免疫细胞产生,通过脑毛细血管通透性增加,使血中的免疫球蛋白进入到脑脊液中。
无乳链球菌是围产期孕产妇及新生儿发生严重感染性疾病的主要病原体之一,在非妊娠成人中,很少致病。但据报道,目前50岁以上的人群特别是有慢性基础疾病的人群,例如糖尿病,中枢系统疾病,免疫低下或缺陷的人,其尤为易感。无乳链球菌是一种条件致病菌,为有荚膜的革兰阳性球菌,根据其特异性荚膜多糖和蛋白抗原进一步分型,目前主要有Ⅰa、Ⅰb、Ⅰa/c、Ⅱ、Ⅲ、Ⅳ、Ⅴ、Ⅵ、Ⅶ、Ⅷ和Ⅸ型[4]。菌株的毒力因子在GBS感染的机制中占主导地位,包括:荚膜多糖、CAMP因子、β-溶血素、菌毛等[5]。荚膜多糖是无乳链球菌的一种主要的毒力致病因子,具有黏附和定植作用,由半乳糖、葡萄糖、氨基葡萄糖和唾液酸4种组分构成[6],其黏附和定植作用可协助无乳链球菌逃逸宿主免疫防御机制[7],引起机体炎性反应。CAMP因子和β-溶血素均为GBS编码两种有穿孔性能的毒素,能促进细胞溶解。同时,无乳链球菌产生的CAMP因子,能促进金黄色葡萄球菌质控菌(25923)的β溶血素溶解红细胞的活性,出现半月形的加强透明溶血区,临床上称为CAMP实验,可以用于无乳链球菌的鉴别试验。随着抗生素的使用,无乳链球菌耐药率也越来越高,主要包括红霉素、克林霉素、四环素等,对青霉素G、头孢噻肟、美罗培南、氧氟沙星、万古霉素等大多抗生素敏感。脑组织结构复杂且具有特异性,特别是血脑屏障的存在使得许多药物难以进入脑组织发挥作用[8]。本例患者血液和脑脊液均培养出无乳链球菌,而大环内酯类,四环素类、氟喹诺酮类、克林霉素类等药物无法透过血脑屏障,因此无法选用。对于革兰阳性菌感染及神经外科术后患者脑脊液的研究发现,利奈唑胺的血脑屏障透过率达70%左右,较万古霉素透过率更高[9] 。
本病例中,患者61岁,有高血压史20年,患者脑脊液检查各项指标均符合化脓性脑膜炎特征,且脑脊液培养为革兰阳性球菌,CAMP阳性,鉴定为无乳链球菌。诊断明确,治疗及时,预后良好。提示对于无乳链球菌引起的急性脑膜炎,易感人群我们不能只局限于新生儿和孕产妇,对于老年人群,特别是合并有慢性基础疾病的人群,其引起的化脓性脑膜炎也不容忽视。慢性基础疾病指慢性代谢性的疾病,包括高血压、糖尿病、慢性阻塞性肺疾病、慢性肾脏病等慢性疾病,患者病情进展为重症和危重症的风险较高。合并的基础疾病越多,身体状态可能就会越差。因此,对于这一类人群,只有早期识别、有效决策和快速治疗才可以挽救生命。
所有作者均声明本研究不存在利益冲突